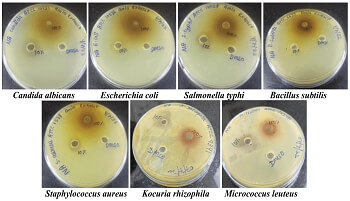

Phyllanthus emblica: A boon or bane - Unlocking the phytopharmaceutical profile
Main Article Content
Abstract
Herbal medicines have been utilised since ancient times to treat various diseases. Medicinal plants have played a significant role in global health, and despite the remarkable progress in modern medicine, plants continue to make a valuable contribution to health. Plants are abundant in tropical regions around the world. Recently, there has been a growing interest in drugs derived from higher plants, especially those used in phytotherapy. It is estimated that about 25% of all modern medicines are directly or indirectly derived from higher plants. In nature, herbs contain a variety of well-arranged medicinal properties. Their uniform medicinal compounds make herbal medicines more effective and of higher quality. Phyllanthus emblica has all the antidiabetic, antimicrobial, DPPH activity and chemical profiling for its potential under the Quality control assessment.
Article Details

This work is licensed under a Creative Commons Attribution-NonCommercial 4.0 International License.
References
- Hassan SM, Mughal A, Farman M. Emblica officinalis (Amla): A prospective review on distinctive properties and therapeutic applications of Amla. Biomedicine and Nursing. 2020, 6(2): 22-30. https://doi.org/10.7537/marsbnj060220.03
- Prathiba S, Rajagopal P, Selvaraj Jayaraman MKP, et al. A Review on Therapeutic Perspectives of Anticancer Properties of Chebulagic Acid. Nveo-Natural Volatiles & Essential Oils Journal. 2021: 7598-7612.
- Indian Pharmacopoeia, 2022. The Indian Pharmacopoeia Commission (ninth edition), Ministry of Health & Family Welfare, Government of India.
- Unigwe R, Okey SN. Medicinal values of the genus Phyllanthus - A review. Journal of Current Biomedical Research. 2023, 3(4). https://doi.org/10.54117/jcbr.v3i4.5
- Sriwatcharakul S. Evaluation of bioactivities of Phyllanthus emblica seed. Energy Reports. 2020, 6: 442-447. https://doi.org/10.1016/j.egyr.2019.08.088
- Liu X, Cui C, Zhao M, et al. Identification of phenolics in the fruit of emblica (Phyllanthus emblica L.) and their antioxidant activities. Food Chemistry. 2008, 109(4): 909-915. https://doi.org/10.1016/j.foodchem.2008.01.071
- Başkan KS, Tütem E, Akyüz E, et al. Spectrophotometric total reducing sugars assay based on cupric reduction. Talanta. 2016, 147: 162-168. https://doi.org/10.1016/j.talanta.2015.09.049
- NOOR MOHAMAD ZIN NS, AZMI NAS, ANUAR NS, et al. A 96-Well-Plate–Based Method for the Estimation of Alpha-Amylase Activity Using Miniaturises 3,5-Dinitrosalicylic Acid (Dnsa) Colorimetric Method. Malaysian Applied Biology. 2022, 51(4): 95-102. https://doi.org/10.55230/mabjournal.v51i4.16
- Panda SK. Screening methods in the study of antimicrobial properties of medicinal plants. International Journal of Biotechnology and Research. 2012, 2(1): 1-35.
- Doughari JH. Antimicrobial activity of Tamarindus indica Linn[J]. Tropical Journal of Pharmaceutical Research. 2006, 5(2): 597-603. https://doi.org/10.4314/tjpr.v5i2.14637
- Al-Snai A E. Iraqi medicinal plants with antibacterial effect-A review. IOSR Journal of Pharmacy. 2019, 9(8): 22-103.
- Johnson DB, Shringi BN, Patidar DK, et al. Screening of Antimicrobial Activity of Alcoholic & Aqueous Extract of Some Indigenous Plants. Indo Global Journal of Pharmaceutical Sciences. 2011, 01(02): 186-193. https://doi.org/10.35652/igjps.2011.18
- Patel P, Joshi C, Kothari V. The Anti-infective Potential of Hydroalcoholic Extract of Phyllanthus emblica Seeds Against Selected Human-pathogenic Bacteria. Infectious Disorders - Drug Targets. 2020, 20(5): 672-692. https://doi.org/10.2174/1871526519666190821154926
- Hsu H, Sheth CC, Veses V. Herbal Extracts with Antifungal Activity against Candida albicans: A Systematic Review. Mini-Reviews in Medicinal Chemistry. 2021, 21(1): 90-117. https://doi.org/10.2174/1389557520666200628032116